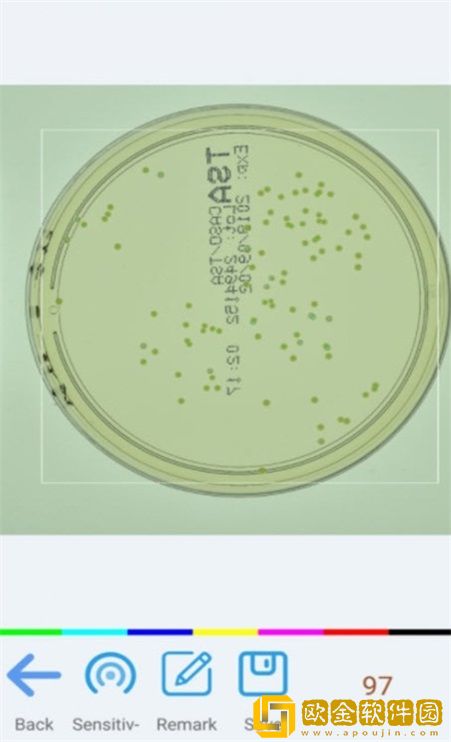
精点相机

精点相机的功能是很棒的为你带来了不同的操作方式还有不同的模式你都是可以来操作和体验一下的,且功能都是免费的,为你带来了很多的修图模板你都是可以直接套用的,所有的用户们都能更好去的享受不同的便捷式的操作和模式了,一键式的功能真的超级方便,滤镜和素材都是免费使用的,为你带来了很多图片编辑的功能!
精点相机app优势
该软件是一款高科技的AI计算拍照功能,即使放大的图片照片也清晰稳定。
可以随时产生想要的照片效果,是一款可以随时提供高质量拍照功能的手机拍照美颜软件。
精点相机让自己的照片效果更好,可以随时为用户的照片带来各种风格设计。

精点相机app特色
对多种形态复杂物品统计准确,可统计具有多种形态物品,如人这种复杂物品也可进行精准统计。
精点相机多分类细微差别统计,可以对两种非常相似的物品进行分类统计,如药品是否残次。
对图片杂物坑干扰性强,在复杂的图片中可以轻松识别目标物体,对其他杂物干扰有很强的过滤效果。
精点相机app亮点
选择一种特别好的颜色或几种颜色一起使用,使图片的颜色更清新,方便用户使用。
精点相机操作方式非常简单,有很多编辑工具。有非常独特的滤镜功能。
如果你想让视频的颜色变得更加突出,你也可以使用不同的程序快速改变不同照片的颜色。

精点相机app优点
在软件中,可以向视频中添加不同的音频,使视频更加精* 。
在软件中,用户不仅可以更改图片的颜色,还可以更改视频中的所有颜色。
软件里面为我们提供多种不同的颜色,可根据我们的拍摄习惯进行更改。
精点相机app特点
软件提供的所有制作工具都非常安全免费,带来了不同的乐趣,上手非常简单轻松。
用户只需快速点击想要修改的照片,即可使用不同的工具进行操作。
任何想要修改自己的视频或图片的用户都可以使用本软件。
精点相机小编点评
精点相机一键式的美颜和修图的模式真的不错哦,享受不同的编辑操作,所有的功能都是免费!